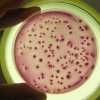
Учени: Животът на човека е силно зависим от бактериалните екосистеми

Новини
Най-старото куче в света почина на 31 години
29.01.2026 10:49Рекордьорът по дълголетие сред кучетата Боби е починал, с което приключи един наистина исторически живот. Той е живял повече от два пъти по-дълго от средната продължителност на живота при кучетата и се превърна в символ на издръжливост и...